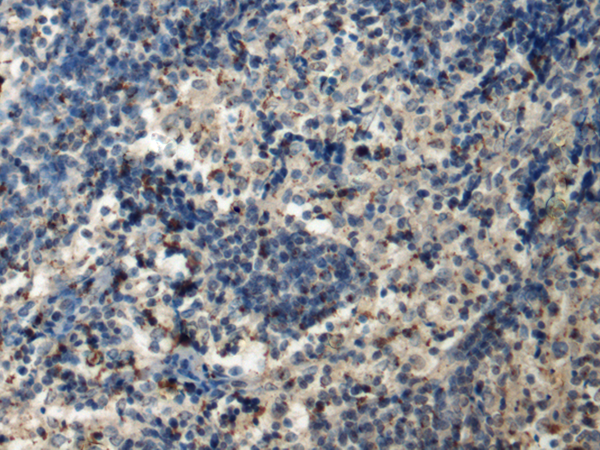
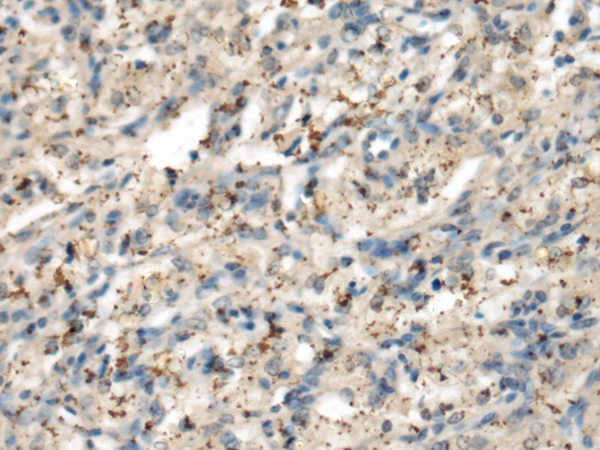
一抗

|
Background: |
This gene encodes the alpha', or alpha 2, catalytic subunit of the protein kinase enzyme, casein kinase 2 (CK2). Casein kinase 2 is a serine/threonine protein kinase that phosphorylates acidic proteins such as casein. It is involved in various cellular processes, including cell cycle control, apoptosis, and circadian rhythms. This heterotetrameric kinase includes two catalytic subunits, either alpha or alpha', and two regulatory beta subunits. The closely related gene paralog encoding the alpha, or alpha 1 subunit (CSNK2A1, Gene ID: 1457) is found on chromosome 20. An intronic variant in this gene (alpha 2) may be associated with leukocyte telomere length in a South Asian population. A related transcribed pseudogene is found on chromosome 11. |
|
Applications: |
ELISA, WB, IHC |
|
Name of antibody: |
CSNK2A2 |
|
Immunogen: |
Fusion protein of human CSNK2A2 |
|
Full name: |
casein kinase 2 alpha 2 |
|
Synonyms: |
CK2A2; CSNK2A1; CK2alpha' |
|
SwissProt: |
P19784 |
|
ELISA Recommended dilution: |
5000-10000 |
|
IHC positive control: |
Human esophagus cancer and Human brain |
|
IHC Recommend dilution: |
100-300 |
|
WB Predicted band size: |
41 kDa |
|
WB Positive control: |
K562 and Jurkat cell lysates |
|
WB Recommended dilution: |
500-2000 |

購物車
購物車 幫助
幫助
 021-54845833/15800441009
021-54845833/15800441009